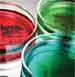

“This is a great study, but it is a preliminary study,” said Jay Pinto, MD, associate professor of otolaryngology-head and neck surgery at the University of Chicago. Dr. Pinto, who wasn’t involved with the research, cautioned that the results will need to be confirmed in a larger group of patients. To zero in on future treatments, clinicians will also need to identify other bacteria that might be key players, along with which mechanisms they use and how their roles may vary in different types of sinusitis.
Explore This Issue
December 2012Despite the remaining holes, Dr. Pinto and other experts said the study could help prompt a broad reconsideration of how microbial communities influence chronic sinus conditions. Robert Kern, MD, professor and chair of the department of otolaryngology-head and neck surgery at Northwestern University Feinberg School of Medicine in Chicago, said the study’s individual findings may be less important than its overall concept. “What this study, in my mind, highlights is that it’s not the specific pathogen but the [bacterial] community that’s reoriented and triggering chronic inflammation within the patient that causes the symptoms,” he said. “It changes how we think of the disease, per se. It’s an excellent effort.”
Bacteria in Balance
The true cause of CRS has long been the subject of fierce debates. Some researchers view the chronic condition, which affects an estimated 30 million Americans and accounts for annual health care costs of more than $2.4 billion, primarily as an immune response that should be treated with anti-inflammatory medications. Others view it as an infectious disease that should be treated with antibiotics.
The latter approach, Dr. Goldberg said, has often employed a “scorched-earth policy,” with the goal of eradicating everything in the sinuses. Clinicians, however, have had to reconsider the “kill everything” strategy in light of recent studies suggesting that the overuse or misuse of antibiotics may have unintended consequences. In 2011, for example, Stanford University researchers demonstrated that giving people the potent antibiotic ciproflaxin twice over a 10-month period led to rapid and profound changes in the gut microbiome, including a loss of bacterial diversity that only partially reverted back to normal (Proc Natl Acad Sci U S A. 2011;108(Supp1):4554-4561).
Leave a Reply